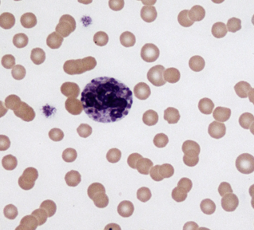

myeloid stem cells
give rise to RBCs, platelets, leukocytes
lymphoid stem cell
gives rise to lymphocytes
basophil morphology
segemented nucleus
granular
basophilic (blue/purple)
rare
relative differential count
do not make interpretations from relative percentages
absolute differential count
/ul
use this for making interpretations
corrected WBC (cWBC)
know this formula
use when nRBC is above reference interval (1-5)

impedence WBC count
WBC impedence count (WIC) must be corrected for nRBCs
use when nRBC is above reference interval (1-5)

optical WBC count
WBC optical count (WOC)
does NOT need to be corrected for nRBC
covert relative WBC to absolute
(WBC relative %) x (total WBC count) = absolute WBC count

how long does proliferation/maturation take in the bone marrow?
5 days
how long are neutrophils in the blood?
10-12hrs
how long are neutrophils in the tissues?
< 2 days
marginal vs circulating WBCs
WBCs that stick to/roll over the walls of vessels
not measured in blood draws

dogs and cats vs cattle and horses neutrophil storage
dogs and cats have more neut storage in marrow
neutrophil regenerative left shift
neutrophilia
increased bands (more immature)
overall more segmented neuts than bands
degenerative neutrophil left shift
more bands than segmented neutrophils
neutropenia
segmented neutrophils are being used up somewhere
overwhelming inflammation
neutrophil deep left shift
can see metamyelocytes or myelocytes (band neutrophil precursors)
toxic neutrophils
early release of neutrophils before maturation is finished
order of toxicity of WBC
- diffuse cytoplasmic basophilia (due to greater amt of RNA)
- Dhole bodies: blue/grey amorphous cytoplasmic inclusions
- toxic vacuolization
- toxic granulation (dust like purple to dark pink)
- donut shaped nucleus
- giant neutrophil (rare)

3 main causes of neutrophilia
- stress (cortisol mediated)
- excitment/physiologic (epinephrine mediated)
- inflammation
stress neutrophilia
MILD neutrophilia
increased cortisol levels (stress, exogenous glucocorticoids, neoplasia)
* storage pool of neutrophils released
* downregulate adhesion molecules and marginal neuts become circulating
no bands, no left shift, no toxicity
also decreased lymphocytes, increased glucose
increased ALP (only in dogs)

excitement/physiologic neutrophilia
mild neutrophilia
* neuts moved from marginal to circulating
* splenic contraction
no left shift
increased lymphs, RBCs, platelets, glucose
fairly transitory, fight/flight response

inflammatory neutrophilia
maturation and storage stores released from bone marrow
recruit marginal pool into area of inflammation
myeloid hyperplasia
left shift, toxic neutrophils
lymphocytosis (if chronic), hyperglobulinemia, hypoalbuminemia

leukemoid response
neutrophil numbers > 50,000/ul (highly increased)
subtype of chronic inflammation
causes:
* IMHA: tissue hypoxia, necrosis
* 5 P’s: Pus, peritonitis, pyothorax, pyelonephritis, pneumonia, paraneoplastic
* hepatozoonosis infection
leukemia-like






